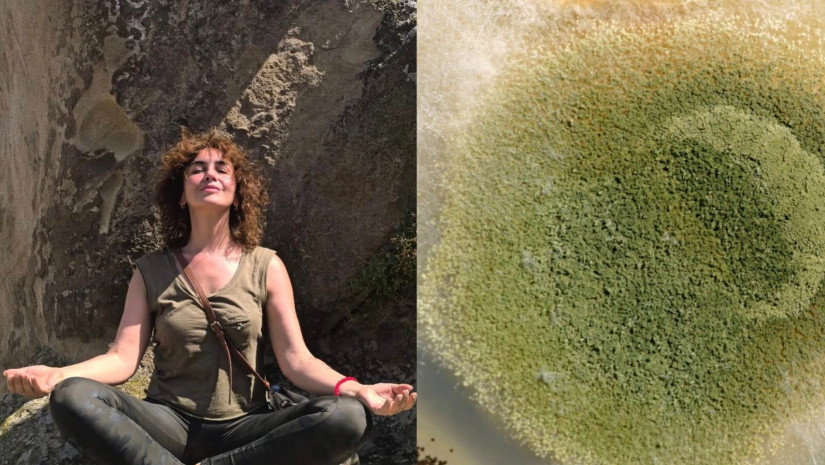
ლალო გელაშვილი

სოკო უხილავი მტერია, რომელიც ხშირად ჩუმად აღწევს ადამიანის ორგანიზმში. მიუხედავად იმისა, რომ სოკოვანი ინფექციები უამრავ ადამიანს აწუხებს, მათი არსებობა ხშირად გვიან გვახსენებს თავს. დაღლილობა, კანის გაღიზიანება, კუჭ–ნაწლავის პრობლემები ან უცნაური ალერგიული რეაქციები - ეს მხოლოდ ზოგიერთი ნიშანია, რომელსაც შეიძლება სოკოვანი ინფექცია ავლენდეს.
როგორ ამოვიცნოთ გვაქვს თუ არა სოკო - ამ თემაზე სოციალურ ქსელში მხატვარი ლალო გელაშვილი წერს და სასარგებლო ინფორმაციას გვიზიარებს:
„სოკოს ნიშნები ადამიანის ორგანიზმში:
1. ყველაფერი, რაც ქავილს იწვევს სოკოა.
ამბობენ:
— ძაღლი დაავადდა.
— რა სჭირს?
— ყური გაუცივდა.
— რას აკეთებს?
— იფხანს. თუ ძაღლი იფხანს ყურს – მას ყურში სოკო აქვს.
თუ ადამიანი იფხანს ყურს ასანთით, კბილის ჩხირით, აქ ერთი ვარიანტია – სოკო. სხვა ვარიანტი არ არსებობს. თუ ქავილია სოკოა.
2. ბზარები, ბუშტუკები, გაღიზიანებები სოკოა.
ყველა ადგილი, რომელიც იფრცქვნება,ან სველდება ერთდროულად, განსაკუთრებით საზარდულის ნაკეცებში.
3. უცნაური გამონაყარი ხელებზე, იღლიებში, საზარდულში სოკოა.
4. ყველაფერი, რაც იქერცლება, წითლდება, იფშვნება — ეს სოკოა.
5.თეთრი, „ხაჭოსებრი“ მსგავსი გამონადენი ყველგან, პირში, ვაგინაში, ბრონქებში — ესეც სოკოა.
6. ენის თეთრი ნადები დილით — ყველაზე ნათლად ჩანს. ეს არის სოკო. ორგანიზმი მთელი ღამე აგროვებს მას ენის ზედაპირზე. ენა უნდა გაიწმინდოს ჩხირით ან კოვზით.
7. ყველაფერი, რაც არ გტკივა, მაგრამ ჩანს. ეს ძალიან მნიშვნელოვანი ნიშანია. სოკო ჭამს ნერვულ დაბოლოებებს.
მაგალითად, ფსორიაზი რომ სტკიოდეს, ადამიანი ვერ აიტანდა. სოკო კი რთავს ამ მგრძნობელობას. სოკო მარტივად ბინადრობს იქ, სადაც არის ლიმფური კვანძები.
ის ცხოვრობს შუალედურ სითხეში, რომელიც ივსება ლიმფით.
თუ სოკო ფეხებზეა, ის ადის ზემოთ - მუხლის ლიმფურ კვანძებამდე. იქ ჩერდება და წყალს აღარ ატარებს. სახსრები სივდება და იწყებს ტკივილს.
რა არ უყვარს სოკოს? – ანტიფუნგალური საკვები: ნიორი, ხახვი. ყველა ანტიპარაზიტული პროდუქტი ერთდროულად ანტისოკოსიც არის.
ფიჭვის, ნაძვის, სოსნის ფისი. ხეები თავს იცავენ სოკოსგან, ამიტომ მათი ფისი ძლიერ ანტიფუნგალურია.
ფისი შეიძლება ჩაიდოს ჩაიში, ნახარშებში, ჩაიში, კომპოტებში, შეიძლება დაღეჭვაც. ეთერზეთები, ჩაის ხის ზეთი, კედრის კაკლის ზეთი.
საჭიროა ცხიმში გახსნა: 1–2 წვეთი.
პროპოლისი ნებისმიერი ფორმით: სპირტიანი, წყლიანი, ფიჭა, დაღეჭვა - მთავარია, მოხვდეს ორგანიზმში.
ანტიგელმინტური და ანტიფუნგალური სანელებლები: წიწაკის ყველა სახეობა. ბოლოკი, ხრენი, კურკუმა, მჟავე.
კენკრები: შავი მოცხარი, წითელი მოცხარი, მოცვი, ჟოლო და ა.შ. თუ შაქარს არ შევურევთ“, - წერს ლალო გელაშვილი.
ასევე დაგაინტერესებთ:
⭕„ცოტა ადრე მომივიდა, მაგრამ ნელ-ნელა გავალამაზებ“ - ნინო ჩხეიძემ ნაძვის ხე დადგა


